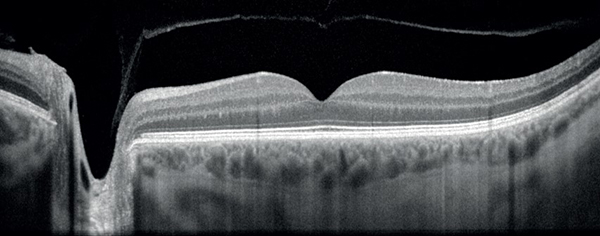
Revo OCT

See your eyes like never before.
We use advanced diagnostic technology during your comprehensive eye examination so we can provide the best care and education to you.
Fundus Photography
Clear ultra-widefield imaging technology capable of capturing retinal pathology.

OCT Scans
High quality cross-section scans that capture the finest details for early disease detection.
Corneal Topography
Revolutionary coloured corneal mapping used to rule out eye disease like keratoconus or assess LASIK candidacy.


AMD Genetic Testing
Early detection and personalized management can reduce the effects of the disease. We offer VitaRisk and MaculaRisk testing.

Slit lamp examination
A powerful microscope used to assess eye disease and abnormalities. Ours is capable of taking pictures and video recording the ocular surface.
From Our Clients

Harbourfront Eye Care
476 Queens Quay West
Toronto, ON M5V2Y3
Monday CLOSED
Tuesday 10:30AM – 6:30PM
Wednesday 10:30AM – 6:30PM
Thursday 10:30AM – 6:30PM
Friday 10:30AM – 3:30PM
Saturday 9:00AM – 2:00PM
Sunday CLOSED
